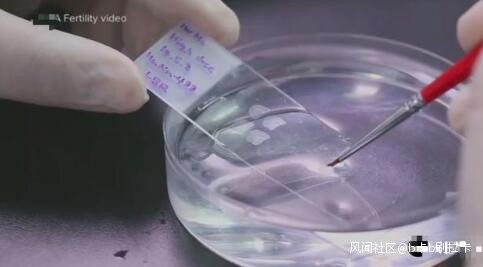

精子用錯了?白人夫婦試管嬰兒生下亞裔寶寶致婚姻破裂_風聞
b卡b刷拉卡-2019-09-14 23:01
網曝白人夫婦試管嬰兒生下亞裔寶寶,用錯精子導致婚姻破裂,亞裔寶寶“親生”父母是誰找到了嗎?孩子撫養權歸誰?一起來看看吧。

白人夫婦試管嬰兒生下亞裔寶寶
據美國媒體9月12日報道,在新澤西州,一對白人夫婦在接受了醫院的生育治療手術後,竟生下了一個亞裔女孩兒,幾年後這對夫婦怒而起訴醫院。
這對夫婦於2012年12月前往該醫院,準備進行試管嬰兒手術。2015年,他們為孩子做了DNA檢測,發現孩子只與母親存在血緣關係,這導致他們在2017年婚姻破裂。
白人夫婦試管嬰兒生下亞裔寶寶
上月底,這對夫婦向法院起訴,狀告為他們提供治療的醫療機構,要求該機構提供生殖基因數據記錄,來尋找該這名亞裔女嬰的“親生”父母。
在蒐集信息的過程中,這對夫婦努力尋找着2012年12月7日期間在該機構工作的人員,以及在2012年12月所有進行試管嬰兒的女性顧客的信息。

白人夫婦試管嬰兒生下亞裔寶寶
而院方表示,他們使用的確實就是這對夫婦的基因,這種情況只有兩種可能性:要麼這個孩子確實就是他們的,要麼這個孩子就是婚外情的產物。
訴訟表明,這個孩子對其真正的父親的身份有知情權,同時她還有權力查明自己是否有任何遺傳疾病。

白人夫婦試管嬰兒生下亞裔寶寶
孩子現在仍由這對夫婦撫養,而此前發生在加利福尼亞的一起類似的案例中,法院則收回了孩子的撫養權。
作為一個私人的醫療機構,其發言人對外表示:“我們是一個充滿熱情和奉獻精神的機構,我們的使命是幫助每一對家長建造起屬於他們的家庭。我們手術過程的每一個步驟都相當精細,嚴密,所以對於此次意外事件,我們會予以重視,配合深入調查瞭解。”
(完)